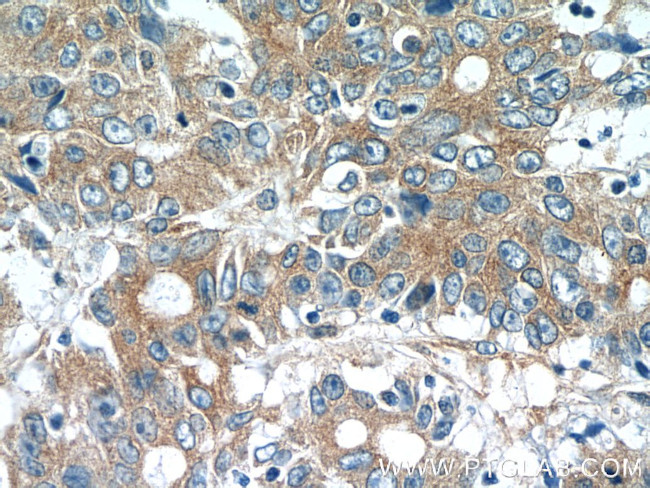
MOBKL3 Antibody in Immunohistochemistry (Paraffin) (IHC (P))

Search
Proteintech
MOBKL3 Polyclonal Antibody
{{$productOrderCtrl.translations['antibody.pdp.commerceCard.promotion.promotions']}}
{{$productOrderCtrl.translations['antibody.pdp.commerceCard.promotion.viewpromo']}}
{{$productOrderCtrl.translations['antibody.pdp.commerceCard.promotion.promocode']}}: {{promo.promoCode}} {{promo.promoTitle}} {{promo.promoDescription}}. {{$productOrderCtrl.translations['antibody.pdp.commerceCard.promotion.learnmore']}}
产品信息
15886-1-AP
种属反应
宿主/亚型
分类
类型
抗原
偶联物
形式
浓度
规格
纯化类型
保存液
内含物
保存条件
运输条件
产品详细信息
Immunogen sequence: MVMAEGTAV LRRNRPGTKA QDFYNWPDES FDEMDSTLAV QQYIQQNIRA DCSNIDKILE PPEGQDEGVW KYEHLRQFCL ELNGLAVKLQ SECHPDTCTQ MTATEQWIFL CAAHKTPKEC PAIDYTRHTL DGAACLLNSN KYFPSRVSIK ESSVAKLGSV CRRIYRIFSH AYFHHRQIFD EYENETFLCH RFTKFVMKYN LMSKDNLIVP ILEEEVQNSV SGESEA (1-225 aa encoded by B C005237)
靶标信息
This gene was identified based on its similarity with the mouse counterpart. Studies of the mouse counterpart suggest that the expression of this gene may be regulated during oocyte maturation and preimplantation following zygotic gene activation. Alternatively spliced transcript variants encoding distinct isoforms have been observed. Naturally occurring read-through transcription occurs between this locus and the neighboring locus HSPE1.
仅用于科研。不用于诊断过程。未经明确授权不得转售。
篇参考文献 (0)
生物信息学
蛋白别名: 2C4D; Class II mMOB1; MOB-like protein phocein; Mob1 homolog 3; MOB1, Mps One Binder kinase activator-like 3; Mob3; Mps One Binder kinase activator-like 3; Phocein; phocein, Mob-like protein; PREI3; Preimplantation protein 3; unnamed protein product
基因别名: 2610109B12Rik; 2C4D; CGI-95; MOB1; MOB3; MOB4; Mobkl1; MOBKL3; phocein; PHOCN; PREI3
UniProt ID: (Human) Q9Y3A3, (Rat) Q9QYW3, (Mouse) Q6PEB6
Entrez Gene ID: (Human) 25843, (Rat) 171050, (Mouse) 19070